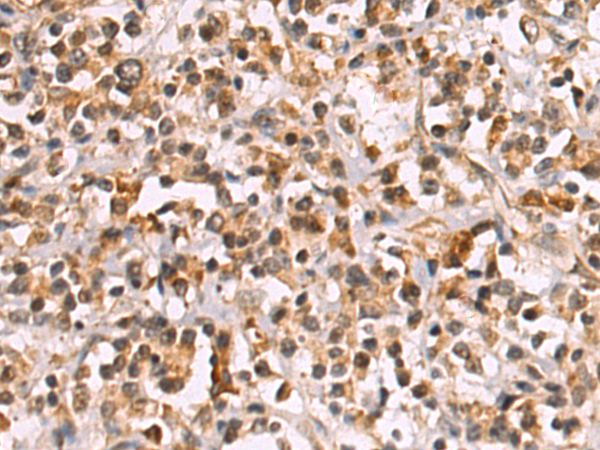

|
Background: |
The uptake of nucleosides by transporters, such as SLC29A2, is essential for nucleotide synthesis by salvage pathways in cells that lack de novo biosynthetic pathways. Nucleoside transport also plays a key role in the regulation of many physiologic processes through its effect on adenosine concentration at the cell surface. |
|
Applications: |
ELISA, WB, IHC |
|
Name of antibody: |
SLC29A2 |
|
Immunogen: |
Synthetic peptide of human SLC29A2 |
|
Full name: |
solute carrier family 29 member 2 |
|
Synonyms: |
ENT2; DER12; HNP36 |
|
SwissProt: |
Q14542 |
|
ELISA Recommended dilution: |
5000-10000 |
|
IHC positive control: |
Human gastric cancer and Human cervical cancer |
|
IHC Recommend dilution: |
25-50 |
|
WB Predicted band size: |
50 kDa |
|
WB Positive control: |
MCF-7 cell lysate |
|
WB Recommended dilution: |
500-2000 |

購物車
幫助
021-54845833/15800441009
